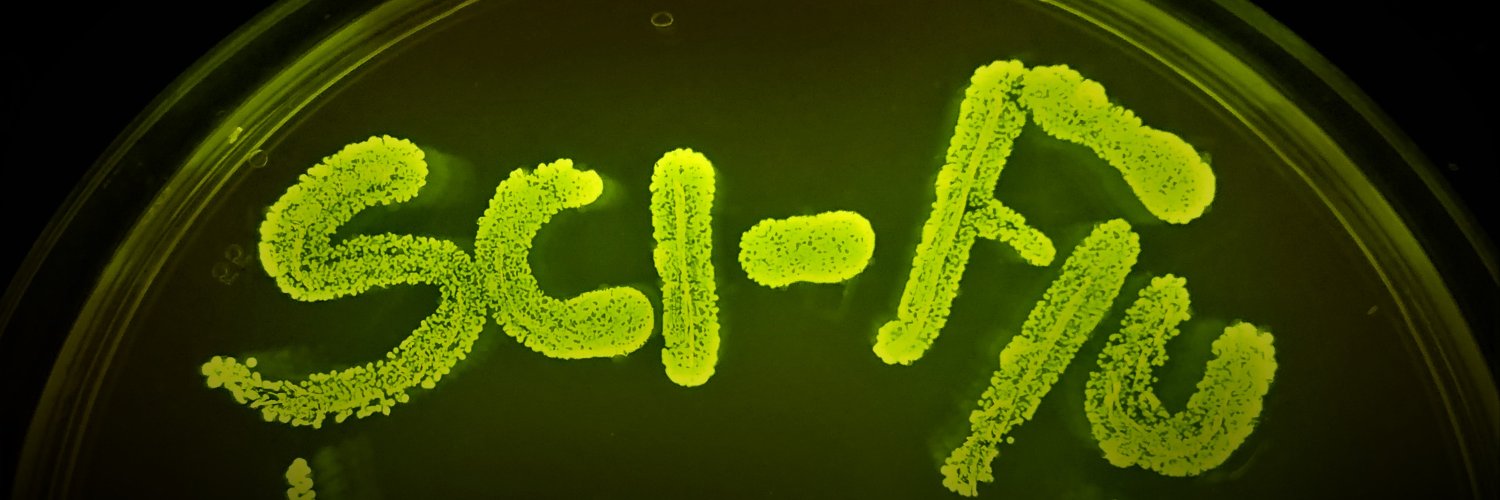
𝕾𝖈𝖎-𝕱𝖑𝖚 🏳️‍🌈 banner

Sabitlenmiş Tweet
𝕾𝖈𝖎-𝕱𝖑𝖚 🏳️🌈
25.4K posts

𝕾𝖈𝖎-𝕱𝖑𝖚 🏳️🌈
@Sci_Flu
Made in lab: 1%Science + 99%Procrastination. Feed Chocolate AND Whisky. Simmering 4 decades. ❤️ for Hobi, TVC'Marius, & everything hilarious, especially life🤪
My neighborhood Graveyard 🪦🕊 Katılım Haziran 2020
44 Takip Edilen226 Takipçiler

@cyb3rpunkt NUUUU I wrote if you "don't" send a picture! OF COURSE I WANT TO SEE YOU WITH THIS HAIR STYLE 😍
English

@cinecrophilia but some of them are nice cuz that's a very polite note, I would have left something WAAAAAY more bitchy 😅
English

@stick_patrol 😂😂😂 OK I take back what I said yesterday, looks like they printing the right book 😅
English

@Sci_Flu I’m sorry your project failed, but I hope you enjoy your consolation prize! 🥃
English

@stick_patrol @Rockstat26 I volunteer to bring the alcohol, fuck the rules 😎
English

@Rockstat26 @Sci_Flu Yes, there’s still room for a different explanation! I’m all for a seance, though. 🥳
English

@Rockstat26 @stick_patrol I hear you 😂😂😂 for me, my fav part of TVC excluding Marius and Armand were the lore & the ancients, so I never moved on from her killing Khayman & the twins and then changing her own lore into something else 😅
English

@stick_patrol @Sci_Flu I mean it can very well still have been a trick of some powerful ghost or spirit (or another yet unknown alien race exists 🤣). we need a seance to summon Anne asap! wdym you died w/o revealing who Memnoch rly was? 😭
English

@stick_patrol 💯 I don't understand but I respect 😎 as my father would say about these crazy times 😂
English

@Sci_Flu 😂😂 Crazy times. I love the last 3 books! Fans have many different opinions, and I think that’s kinda fun!🤷🏻♀️
English

This made me LOL cuz my passion for BDSM was not born when I got unsupervised access to internet at the age of 13, in 1999, but when at 16 I found Philosophy in the Boudoir at the public library. Truth is, an alarming amount of genz are just dumb, no wonder ½ them are fascists 💀
dawn 🌄@dawnofthefemme
stop acting dense lmfao i’m an older gen z who grew up on millennial spaces, i was 12 on tumblr and twitter being incentivized by older people into reading Lolita and making the rice purity/BDSM tests. i developed a daddy kink at 14. you’re purposely being obtuse
English

@stick_patrol Oh true! Gosh the timing of this illustrated TVL... IWTV about to turn 50 but they printing the wrong book 😅
English

@Sci_Flu Wouldn’t that be nice! Or maybe news about the upcoming illustrated version of TVL??
English

@cyb3rpunkt He knows and sees everything (and seems like Hudson is the same LOL)
English

@Emylee4111 I have 5 wips, but if I'm done within 5 years I might give it a thought 😂
English







